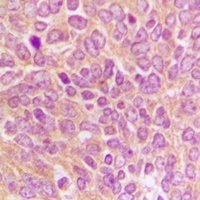
产品细节图片2

相关产品推荐更多 >
万千商家帮你免费找货
0 人在求购买到急需产品
- 详细信息
- 文献和实验
- 技术资料
- 抗体名:
Caspase 9 p35 Antibody抗体
- 抗体英文名:
Caspase 9 p35 Antibody
- 应用范围:
IF, IHC, WB
- 宿主:
Rabbit
- 适应物种:
Human, Mouse
- 保质期:
6-12个月
- 抗原来源:
详询
- 目录编号:
orb304709
- 级别:
科研级
- 库存:
88
- 供应商:
biorbyt
- 标记物:
Unconjugated
- 克隆性:
Polyclonal
- 形态:
Liquid in 0.42% Potassium phosphate, 0.87% Sodium chloride, pH 7.3, 30% glycerol, and 0.01% sodium azide.
- 免疫原:
KLH-conjugated synthetic peptide encompassing a sequence within the C-term region of human Caspase 9 p35. The exact sequence is proprietary.
- 规格:
30 ul
别名:CASP9; MCH6; Caspase-9; CASP-9; Apoptotic protease Mch-6; Apoptotic protease-activating factor 3; APAF-3; ICE-like apoptotic protease 6; ICE-LAP6
免疫原:KLH-conjugated synthetic peptide encompassing a sequence within the C-term region of human Caspase 9 p35. The exact sequence is proprietary.
应用稀释比例:WB: 1:500-1000, IHC-P: 1:100-200
纯化:The antibody was purified by immunogen affinity chromatography.
保存说明:Maintain refrigerated at 2-8°C for up to 2 weeks. For long term storage store at -20°C in small aliquots to prevent freeze-thaw cycles.
Entrez:842, 12371
UniProt ID:P55211, Q8C3Q9
Note:For research use only.

风险提示:丁香通仅作为第三方平台,为商家信息发布提供平台空间。用户咨询产品时请注意保护个人信息及财产安全,合理判断,谨慎选购商品,商家和用户对交易行为负责。对于医疗器械类产品,请先查证核实企业经营资质和医疗器械产品注册证情况。
 文献和实验
文献和实验细胞因子的激活和炎症反应(见第七章)。而且,参与诱导凋亡的caspase分成两大类:启动酶(initiator)和效应酶(effector),它们分别在死亡信号转导的上游和下游发挥作用。经FADD激活的caspase 8属于启动酶。其他的启动酶还有caspase 9(参与线粒体介导的凋亡)和caspasel0(和颗粒酶诱导的凋亡有关)。Caspase的活性 受CrmA、杆状病毒蛋白P35、人XIAP蛋白及特异抑制性多肽DEVD―CH()等调节。
一 caspase家族蛋白酶的组成 未活化的caspase家族蛋白酶是以酶原形式存在的,酶原的氨基端有一段被称为“原结构域”(pro-domain)的序列。酶原活化时不但要将原结构域切除,并且要将剩余部分剪切成一大一小两个亚基,分别称为P20和P10,活性酶就是由这两种亚基以(P20/P10)2的形式组成的。这种活化反应也是Asp特异的,剪切发生在酶原中保守序列的Asp与其后的氨基酸残基
。分子中的羧基侧链部可构成“结合袋”,参与识别并结合底物分子。 Caspase 1旧称Ⅱ/―1p转换酶(1CE),可在hs和TNFRl介导的细胞凋亡中起作用。hs和TNFRl信号可活化ICE酶原。此外,ICE样蛋白酶还参与其他多种因素诱导的凋亡,如细胞外基质丧失以及化疗药物如顺铂等诱导的凋亡。 CrmA是ICE的特异性抑制物。p35也可通过与ICE形成p35―ICE复合物而抑制细胞凋亡。此外,一些根据ICE作用底物设计的小肽如乙酰―Tyr―Val―A19…Asp―氯
 技术资料
技术资料暂无技术资料 索取技术资料










